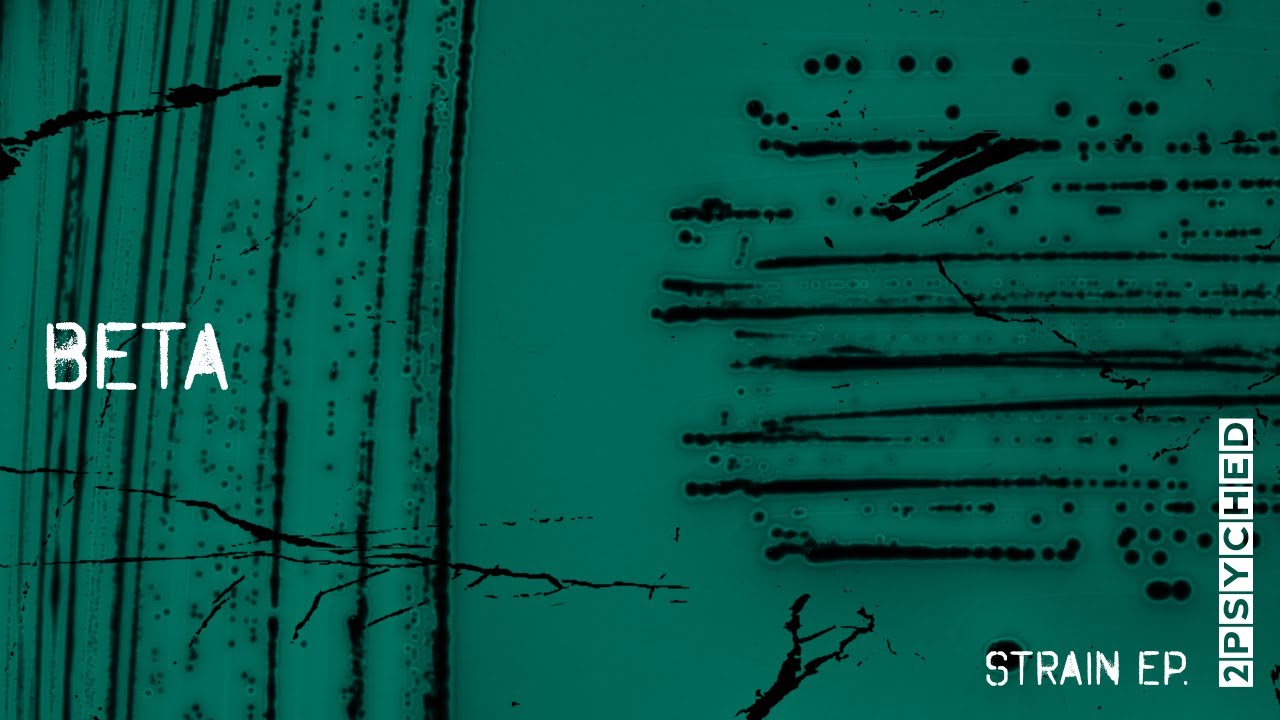

Melodicness
How much the song possesses a clear and memorable tune that follows well-defined musical patterns. A song high in melodicness generally features clear and memorable instrumental or vocal lines.
Acousticness
A measure of how much a song relies on acoustic instruments (eg. piano, guitar, violin, drums, saxophone) instead of electronic or digitally synthesized
Valence
The musical positivity or emotional tone conveyed through the song's harmonic and rhythmic components. High valence corresponds to feelings of happiness, excitement, and euphoria while low valence is associated with sadness, anger, or melancholy.
Danceability
A combination of factors including tempo stability, rhythmic patterns, and beat emphasis to determine how suitable a song is for dancing. A "danceable" song may feature a consistent tempo, repetitive musical structure, and strong downbeats.
Energy
The perceived intensity of a track which may be influenced by tempo, dynamics, and musical compactness. A high energy song may have a driving rhythm and dense instrumentation while a low energy song can be musically sparse and feature slower tempos.
BPM134
Music Video
Music Video
Credits
PERFORMING ARTISTS
2psyched
Performer
COMPOSITION & LYRICS
Scott Vizarra
Composer